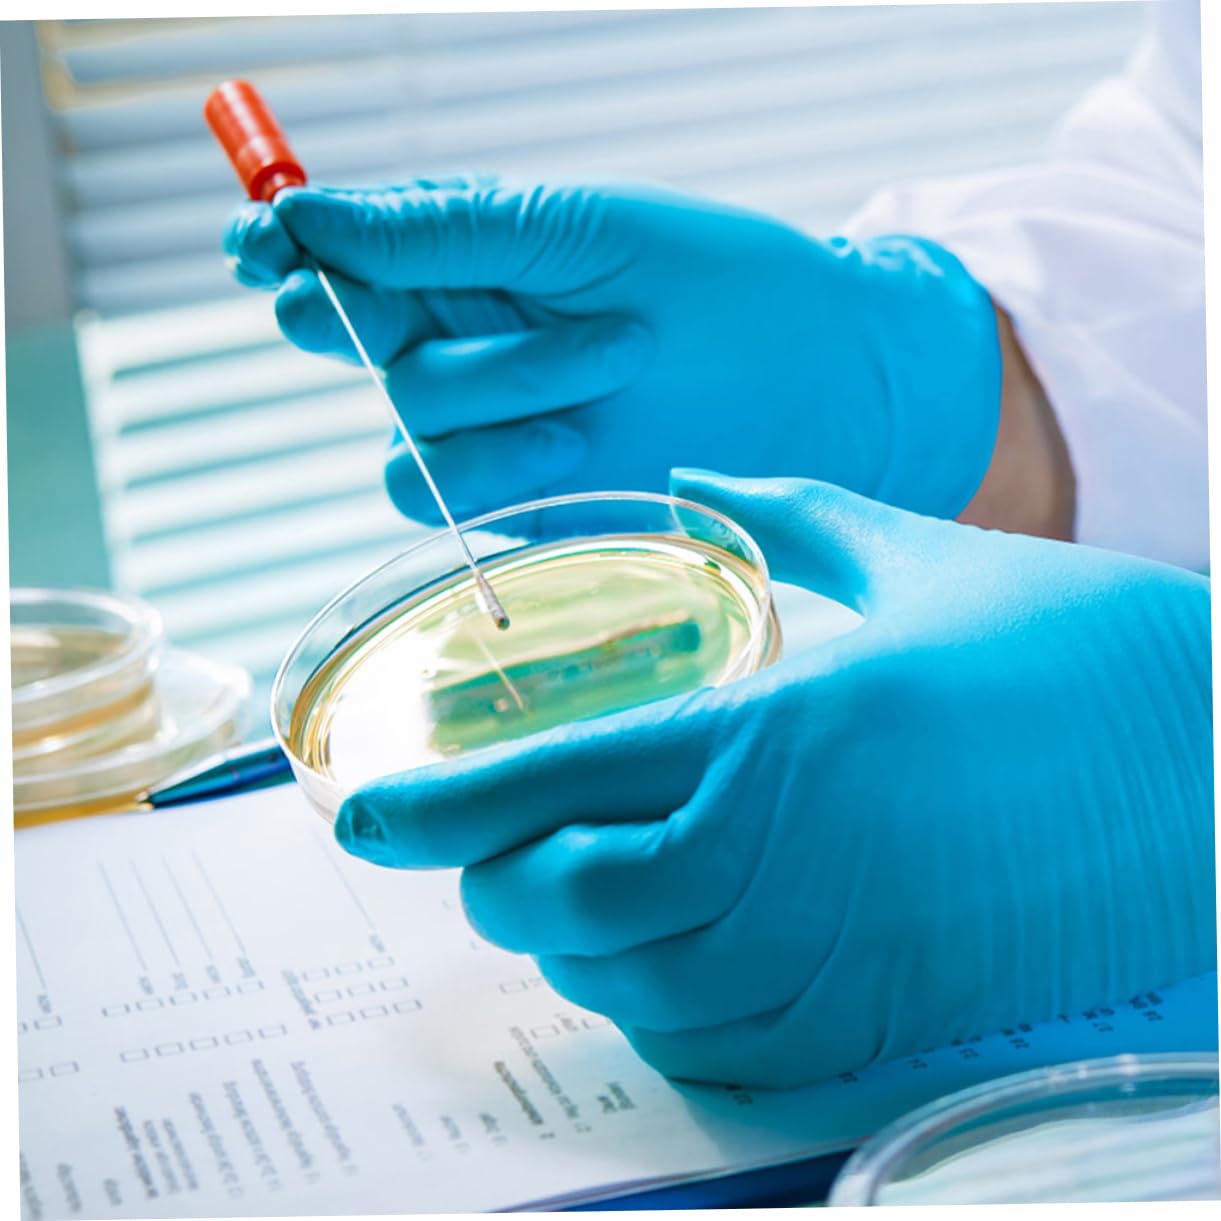
COSMEVIVI 10pcs Culture Plate Plant Petri Dish Agar Petri Dishes Culture Dishes with Lids for Science Petri Dishes with Lid Analysis Dish Petri Dish Plates Experiment Dish Lab Dishes Plastic

Product Information
Specification
Brand : COSMEVIVI
BulletPoint1 : Cell tissue culture tray-- suitable for any home, school or laboratory use, enough quantity for you to use and replace,tissue culture dishes
BulletPoint2 : Green stapler-- featuring clear color and smooth surface, these petri dishes are helpful to ensure that your samples are safe,lab petri dishes
BulletPoint3 : Science experiment container-- this petri dish plate are excellent and and useful function, suitable for research use,
BulletPoint4 : Agar dish-- adopted of plastic material, it is practical and for long time use, bring you much conveniences,laboratory dish
BulletPoint5 : Plastic petri dish-- clear appearance and low expansion rate, moderate thickness, not easy to broke, practical and excellent,bioresearch tissue
Capacity : 50 milliliters
Color : As Shown
CustomerPackageType : Standard Packaging
ExternallyAssignedProductIdentifier1 : 193206015623
ExternallyAssignedProductIdentifier2 : 0193206015623
ItemDisplayDimensions_Length : 3.54 centimeters
ItemDisplayWeight : 0.32 pounds
ItemName : COSMEVIVI 10pcs Culture Plate Plant Petri Dish Agar Petri Dishes Culture Dishes with Lids for Science Petri Dishes with Lid Analysis Dish Petri Dish Plates Experiment Dish Lab Dishes Plastic
ItemPackageDimensions_Height : 3.15 inches
ItemPackageDimensions_Length : 7.87 inches
ItemPackageDimensions_Width : 3.94 inches
ItemTypeKeyword : science-lab-petri-dishes
ItemVolume : 1 cubic_centimeters
Manufacturer : COSMEVIVI
Material : plastic
ModelNumber : 41VOT2503QCLA
NumberOfItems : 1
NumberOfLithiumMetalCells : 1
NumberOfPieces : 4
PartNumber : 41VOT2503QCLA
ProductDescription : Package List
10 x Petri Dishes with Lids
Characteristics
- Size: 9.00X9.00X2.00cm/3.54X3.54X0 laboratory cell culture
- Color: As Shown culture plate for lab
-Material:Plastic clear culture plate
- You will have good use experience because of the workmanship of this product tissue culture dish.
- This culture plate are suitable for researchers to do experiments, wonderful for cell culture use petri dish with lid.
- Laboratory analysis for medical, , scientific research and other activities, suitable for general petri dishes.
- Suitable for laboratory analysis, scientific research and other activities cell culture bags.
- Adopt excellent transparency, excellent performance, corrosion resistance and heat resistance science laboratory supply.
Goods Description
petri dish with lid This culture plate are suitable for you to do experiments for cell culture, useful and reliable.petri tissue culture dish At the same time, it is more portable and can be reused, excellent and wonderful for laboratory.clear petri dish These cell culture dishes are made of plastic with a smooth surface that is easy to clean and reusable.laboratory cell culture plate Culture plate is useful and practical for experiment use
ProductSiteLaunchDate : 2024-10-07T20:00:50.339Z
Size : 9.00X9.00X2.00CM
Style : 50mL, 4-pack
SupplierDeclaredDgHzRegulation : not_applicable
UnitCount : 1
UnspscCode : 52151600